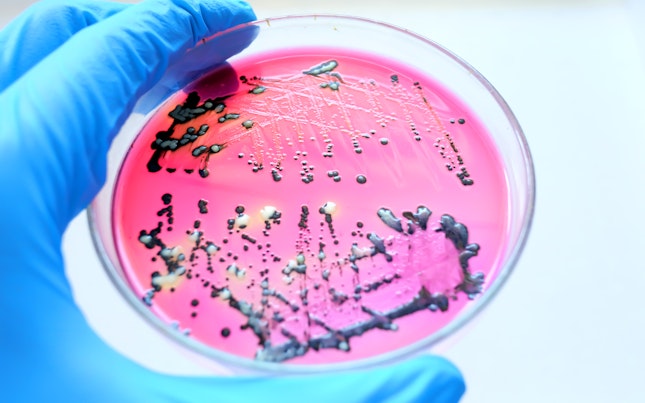
Close Up Black Colonies of Salmonella Bacteria

Food safety and quality are of utmost importance. Microbiology testing ensures the foods we consume are free from the harmful microorganisms – bacteria, viruses, molds, yeasts, parasites, etc. – that cause foodborne illnesses. Rigorous testing detects and quantifies these microorganisms. It provides vital information to allow food manufacturers, regulators and consumers to make informed decisions and apply risk reduction strategies that prevent outbreaks and protect public health.

Comprehensive solutions
We offer the full range of food microbiology testing services, delivered through a global network of state-of-the-art laboratories. Utilizing the latest methodologies and techniques, our highly trained experts will detect and identify the microorganisms that can spoil food and may pose a risk to human health. We cover a broad spectrum of pathogens, including bacteria, viruses, molds, yeasts and parasites, as well as other indicator and spoilage microorganisms.
Our testing procedures can be applied to a diverse range of food products – fresh produce, dairy, meat, poultry, seafood and processed food – and encompass both qualitative and quantitative methods. Through advanced molecular techniques such as PCR and DNA sequencing, we can determine the presence/absence of even the most elusive specific microorganisms, before measuring their levels in a sample.
Looking for something specific?
Search within Food Microbiology
11-12F, Cheongryong Building, 257, Hangang-daero, Galwol-dong, Yongsan-gu, Seoul, Republic of Korea,
Seoul, Korea, Republic of